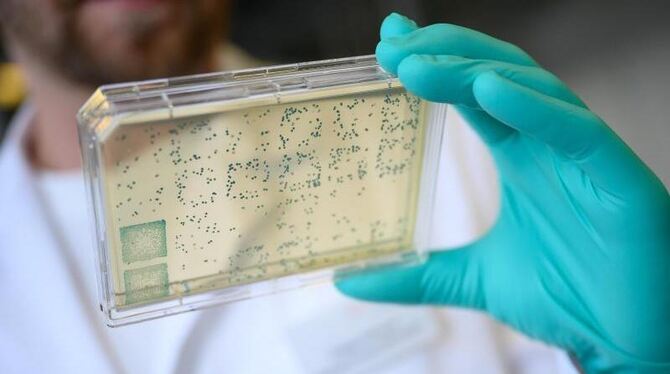
Impfstoff

BERLIN. Bundeskanzlerin Angela Merkel hat zu einer internationalen Zusammenarbeit bei der Suche nach Medikamenten und Impfstoffen für die Eindämmung von Corona-Infektionen aufgerufen.
»Heute fehlen für die Entwicklung eines Impfstoffes noch geschätzt acht Milliarden Euro«, sagte die Kanzlerin in ihrer wöchentlichen Videoansprache (Podcast). Sie blickte dabei auf die Geberkonferenz am 4. Mai, zu der die EU-Kommission eingeladen hat. Deutschland werde sich mit einem »deutlichen finanziellen Beitrag beteiligen«, den sie aber noch nicht benennen wolle.
Zu den Folgen der Pandemie sagte Merkel: »Wir wissen, dass sie überall schwere Schäden auch unserem wirtschaftlichen, sozialen, gesellschaftlichen Leben zufügt. Deshalb müssen wir mit Hochdruck und großer Konzentration daran arbeiten, dieses Virus einzudämmen und dann auch zu besiegen, indem wir einen Impfstoff entwickeln.« Das gehöre zu den vornehmsten Aufgaben, um Millionen von Menschenleben zu retten.
»Deutschland stellt sich dieser Veranwantwortung und deshalb werden wir auch dafür Sorgen tragen, dass ein Impfstoff allen Menschen zugutekommt, wenn er einmal entwickelt wurde, und auch die Medikamente, die notwendig sind, und die Diagnosemöglichkeiten möglichst vielen zugutekommen«, sagte Merkel. Sie begrüßte, dass nun ein großes Bündnis aus Regierungen und privaten Stiftungen zusammenarbeiten werde, um so unter anderem die Entwicklung und Herstellung von Impfstoffen und Medikamenten zu ermöglichen. (dpa)